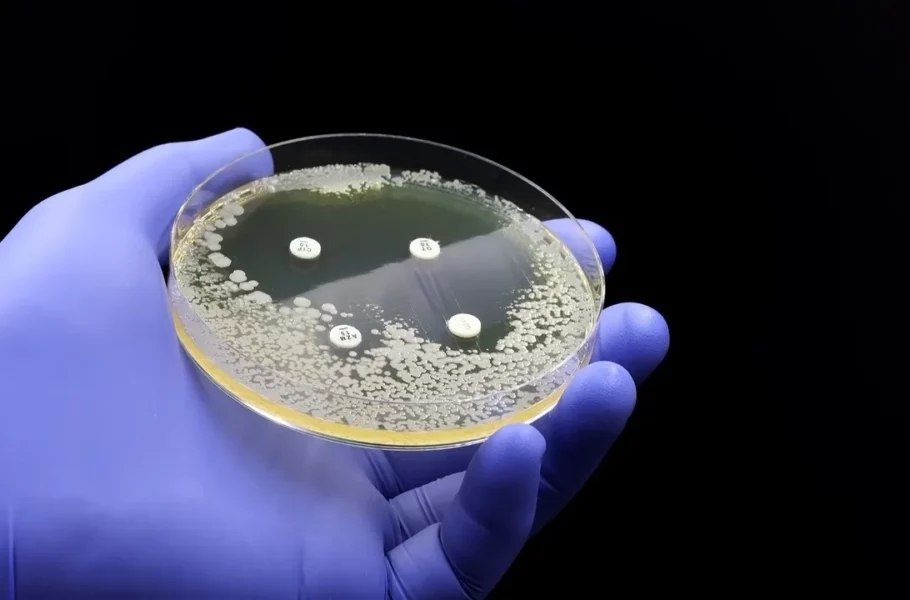
مطالعه جدید: دیابت می‌تواند مقاومت به آنتی‌بیوتیک‌ را افزایش دهد

موش پشمالو، گامی بزرگ به سوی بازسازی ماموتها
یزدفردا: شرکت انقراض زدایی کلوسال Colossal جهشهای ماموت و موش را در یک سویه مخلوط کرد تا جوندهای با موهای کرکی ایجاد کند. این شر ...
کشف جدید «جیمز وب» درباره قرصهای پیشسیارهای
یزدفردا: مشاهدات «تلسکوپ فضایی جیمز وب» نشان میدهند که قرصهای پیشسیارهای میتوانند بیشتر از حد تصور دوام بیاورند. ...
غذایی که از پیشرفت « ام اس» جلوگیری میکند
یزدفردا: یک مطالعه جدید نشان می دهد که رژیم غذایی غنی از ماهی ممکن است پیشرفت بیماری مولتیپل اسکلروزیس (ام اس) را در برخی بیماران ...
چهار تا از بهترین ویتامینها برای بهبود روده تحریکپذیر و تقویت گوارش
یزدفردا: یکی از راههای درمان یا بهبود علائم روده تحریکپذیر رژیم غذایی متعادل است. منظور از رژیم متعادل رژیمی است که تمامی مواد ...
بازگرداندن بینایی به روشی عجیب؛ جراحان دندان بیمار کانادایی را در چشم او قرار میدهند!
یزدفردا: جراحان برای بازگرداندن بینایی مرد کانادایی عمل بسیار نادری انجام دادهاند. در این روش عجیب از دندان خود بیمار برای ایجاد ...
راز پنهان در فرمول ۱۰۰ساله؛ کشفی که صنعت انرژی را متحول میکند!
یزدفردا: یک دانشجوی جوان با بازبینی یک مسئله ریاضی یک قرنی، راهحلی ساده اما هوشمندانه برای بهینهسازی جریان هوای توربینهای بادی ...
خواص اعجاب آور «گل کلم»
یزدفردا: اگرچه همه سبزیجات به سلامتی کمک میکنند، اما تمام سبزیجات خاصیت پیشگیری از بیماریهای خطرناک را ندارند! ...
طراح بمبگذاری در شاهچراغ، کرمان و فرودگاه کابل دستگیر شد؛ پاکستان او را به آمریکا تحویل داد
یزدفردا: نیروهای امنیتی پاکستان چهارشنبه عضو ارشد داعش خراسان محمد شریفالله را طی عملیاتی در مرز افغانستان دستگیر کردند، فردی که ...
ماه گرفتگی خونین در آسمان شب
یزدفردا: اولین ماه گرفتگی کامل از سال ۲۰۲۲ تا کنون، قرار است در روزهای ۱۳ تا ۱۴ مارس سال ۲۰۲۵ آسمان شب را زیبا کند اما تنها کسانی ...
حسن یزدانی همچنان بین بهترینهای جهان است!
یزدفردا: در جدیدترین رنکینگ اتحادیه جهانی کشتی دو آزادکار و دو فرنگی کار ایرانی در صدر جدول برترینها قرار دارند. ...
انجام سالانه ۵ تریلیون جستوجو در گوگل
یزدفردا: گوگل برای اولین بار از سال ۲۰۱۶، دادههای جدیدی را به اشتراک گذاشت و اعلام کرد این موتور جستوجو، بیش از پنج تریلیون جست ...
این آنتی بیوتیکهای طبیعی را به رژیم غذایی خود اضافه کنید
یزدفردا: آنتی بیوتیکها مراقبتهای بهداشتی را دگرگون کردهاند، میلیونها نفر را از عفونت باکتریایی نجات دادند و در نتیجه جان آنها ...
نانوذرات اکسیدآهن، جایگزینی امیدبخش برای درمان کانال ریشه دندان
یزدفردا: پژوهشگران دانشگاه پنسیلوانیا موفق شدند با استفاده از نانوذرات اکسیدآهن، راهکاری نوین برای درمان پریودنتیت آپیکال ارائه ده ...
موفقیت قرص گیاهی مبتنی بر زرشک در کنترل دیابت نوع 2
یزدفردا: یک قرص گیاهی جدید که شاکله آن از مادهای موجود در زرشک تشکیل شده است، در آزمایشات انسانی برای کنترل دیابت نوع 2 امیدوارکن ...
برنامه مسابقات مهم ورزشی امروز چهارشنبه ۱۵ اسفند؛ طارمی آزمون و ۳ مسابقه نفسگیر دیگر
یزدفردا: مسابقات و رویدادهای مهم ورزشی امروز در زیر میتوانید ببینید. ...
تاثیر ورزش در افزایش طول عمر بازماندگان سرطان روده بزرگ
یزدفردا: یک مطالعه جدید نشان می دهد که ورزش منظم می تواند به بازماندگان سرطان روده بزرگ کمک کند تا عمر طولانی تری داشته باشند، شای ...
سیارهها یک هفته به خط میشوند
یزدفردا: یکی از اتفاقات جذاب فضایی که از دیروز بیش از یک هفته فضا را تحت الشعاع قرار میدهد «رژه سیاره ها» است. آخرین روزهای دومین ...
طلوع خورشید روی ماه
یزدفردا: فرودگر قمری «شبح آبی» پس از فرود تاریخساز خود روی ماه، یک عکس شگفتانگیز را از طلوع خورشید ثبت کرد. ...
آشفتگی در کاخ سفید؛ سرگیجه در سیاست جهانی
یزدفردا: گمانهزنیهای فراوانی درباره مشاجره ترامپ و زلنسکی وجود دارد. آیا این درگیری عامدانه طراحی شده بود؟ یا از کنترل خارج شد؟ ...
دم کردن چای می تواند فلزات سنگین را از آب فیلتر کند
یزدفردا: بر اساس آخرین تحقیقات، دم کردن چای به حذف فلزات سنگین مانند سرب و کادمیوم با فیلتر کردن طبیعی آنها از آب کمک می کند. ...
کاهش قند خون با کلم بروکلی
یزدفردا: تحقیقات جدید نشان می دهد که ترکیب موجود در جوانه کلم بروکلی ممکن است در درمان پیش دیابت موثر باشد. ...
کشف محدودیتهای جدید برای خواص ماده تاریک
یزدفردا: طیفنگارهای پیشرفته، سختترین محدودیتها را برای طول عمر ماده تاریک ارائه دادهاند. ...
کشف اجرام یخی مرموز در محیط میانستارهای
یزدفردا: پژوهشگران ژاپنی در اکتشافات خود به اجرام مرموز یخی در محیط میانستارهای رسیدهاند که حاوی آب و مولکولهای آلی هستند. ...
کشف مهم محققان: خود فرایند تکامل نیز میتواند درحال تکامل باشد
یزدفردا: محققان با شبیهسازیهای کامپیوتری نشان دادند خود فرایند تکامل میتواند متناسب با فشارهای محیطی تکامل پیدا کند؛ یعنی نهفق ...
مطالعه جدید: دیابت میتواند مقاومت به آنتیبیوتیک را افزایش دهد
یزدفردا: باکتریها میتوانند عفونتهای خطرناکی ایجاد کنند. بدتر اینکه بسیاری از این باکتریها به آنتیبیوتیکها مقاوم شدهاند. این ...
خروج موتا از فشار با پیروزی یوونتوس مقابل ورونا
یزدفردا: یوونتوس با گلزنی خفرن تورام و تون کوپماینرز موفق به شکست ۲-۰ ورونا در هفته بیست و هفتم رقابتهای سری آ ایتالیا شد. ...
برنامه مسابقات مهم ورزشی امروز سهشنبه ۱۴ اسفند؛ دربی مادرید در کنار تراکتور
یزدفردا: مسابقات و رویدادهای مهم ورزشی امروز در زیر میتوانید ببینید. ...
چاقی در مغز آغاز میشود!
یزدفردا: مطالعهای جدید نشان میدهد که مغز نقش اساسی در ایجاد چاقی دارد. ...
تاریخ دقیق خاموش شدن خورشید
یزدفردا: خورشید، ملکه ستاره منظومه شمسی است و به لطف آن همه ما امروز اینجا هستیم، زیرا مسئول روشنایی و گرم کردن سیاره ما است. ...
شکست میلان مقابل لاتزیو؛ آژیر قرمز برای کونسیسائو هم درآمد
یزدفردا: روزهای سیاه سرجیو کونسیسائو و میلان ادامه دارد و در ادامه این روند این تیم با نتیجه ۲-۱ مقابل لاتزیو شکست خورد. ...
جهان در شوک؛ بوایسار سایتی اف درگذشت
یزدفردا: نابغه سابق کشتی جهان و دارنده ۹ مدال طلای جهان و المپیک در سن ۴۹ سالگی درگذشت. ...
برنامه مسابقات مهم ورزشی امروز دوشنبه ۱۳ اسفند؛ استقلال مقابل النصر
یزدفردا: مسابقات و رویدادهای مهم ورزشی امروز در زیر میتوانید ببینید. ...

یکشنبه 14,دسامبر,2025